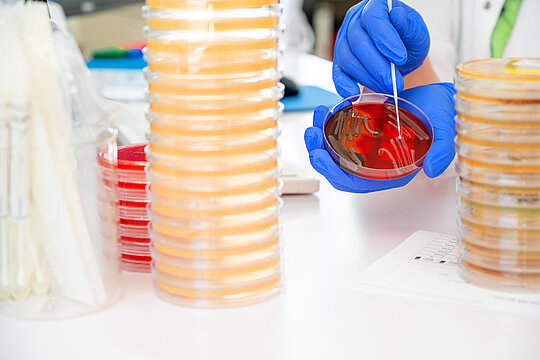
Leistungsspektrum

Die medizinische Mikrobiologie studiert die Biologie pathogener Mikroorganismen und deren Mechanismen sich im menschlichen Körper anzusiedeln und Infektionskrankheiten auszulösen. Auch im Zeitalter des modernen Menschen stellen Infektionskrankheiten die häufigste Todesursache weltweit dar. Damit wird einmal mehr die Bedeutung dieses wissenschaftlichen Fachs deutlich. Im Rahmen der Krankenversorgung sind wir in erster Linie für die Diagnostik zuständig, welche sich schwerpunktmäßig auf Untersuchungen in der Bakteriologie, Virologie, Parasitologie und Mykologie konzentriert.
Kontakt
Department für Labormedizin, Abt. III
Ärztliche Leitung / Laborleitung: PD Dr. med. Matthias Karrasch
Magdeburger Straße 6 (Labor für Bakteriologie, Parasitologie, Mykologie)
06112 Halle (Saale)
weitere Standorte:
Labor Infektionsserologie, Magdeburger Straße 18
Labor für Molekulare Diagnostik, Weinbergweg 22 (akkreditierte Einrichtung)
Telefon: 0345 557 1809
Mail: mikrobiologie☉uk-halle.de